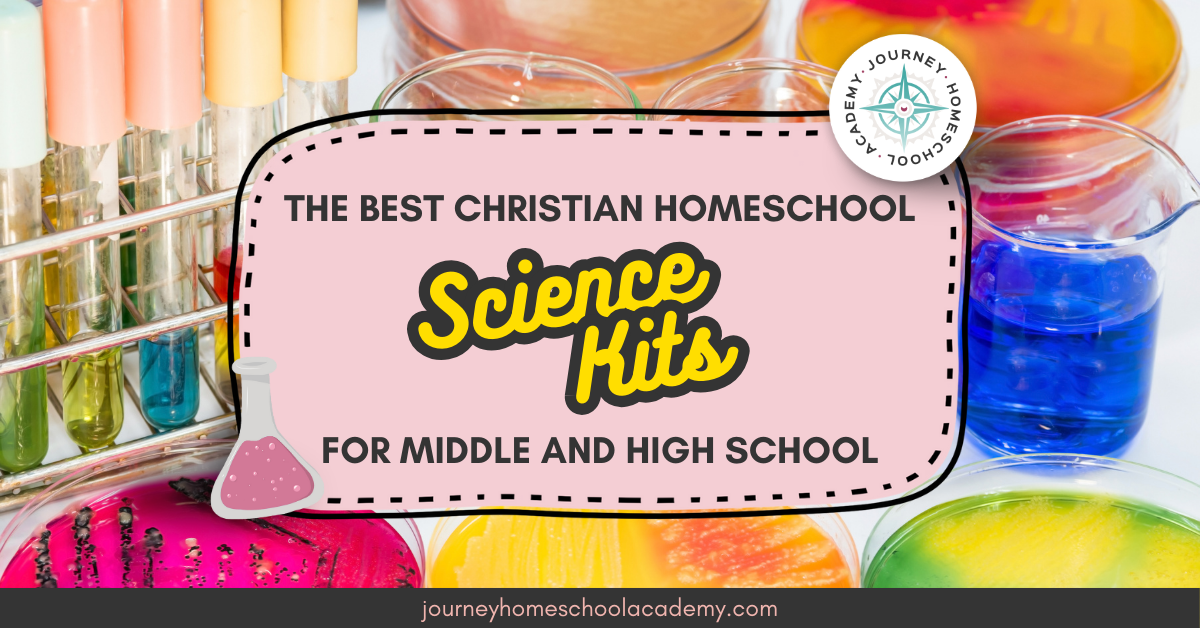
The Best Christian Homeschool Science Kits for Middle and High School - Journey Home School Academy

When we talk to homeschool parents (or parents who wish they could homeschool), science almost always comes up as one of the most intimidating subjects. Parents are usually pretty confident about teaching the alphabet, phonics, and even basic math. But when it comes to science experiments? Suddenly, many want to run and hide!
Maybe you remember your own high school science days. Maybe you enjoyed the thrill of chemistry labs—Bunsen burners, beakers, and chemical reactions. Or perhaps you loved the hands-on side of biology—dissecting a frog, marveling at how intricate God’s creation really is. But now as a homeschool parent, you might be wondering: How on earth can I replicate all that equipment at home?
Here’s the good news: you don’t have to.
The Best Christian Homeschool Science Kits for Middle and High School

That’s where Christian homeschool science kits come in. These ready-made kits give you all the supplies you need, paired with a curriculum that integrates faith and rigorous science. It’s no wonder these kits are flying off the shelves—they save parents time, reduce stress, and give students exciting, hands-on experiences that bring science (and Scripture!) to life.
Why Christian Homeschool Science Kits Are in Such High Demand
Let’s face it—teaching science can feel overwhelming. From finding the right equipment to knowing whether you’re even “doing it right,” it’s enough to make many parents second-guess themselves. Add in the desire to teach science through a distinctly Christian worldview, and the task feels even more daunting.
That’s why science kits are becoming a homeschool must-have:
- They save time. No more hunting down obscure lab supplies at five different stores.
- They reduce stress. Everything your child needs is neatly packaged and ready to go.
- They make learning fun. Hands-on experiments keep kids engaged and curious.
- They support faith-based learning. The best kits tie discoveries about the natural world back to the Creator.
At Journey Homeschool Academy, we design our science courses to include labs, hands-on activities, and supply recommendations that make life simpler for parents. Pair those with quality kits, and you’ll have everything you need for successful (and joyful) science learning at home.

The Best Christian Homeschool Science Kits for Middle and High School
Our elementary-level courses use everyday household supplies—so no lab kits are required. For middle and high school, we provide a clear list of supplies that can be gathered at home, and our courses can absolutely be completed without purchasing a lab kit. However, for families who want the convenience of a ready-made solution, our optional lab kits make the process simple and stress-free. Here’s a guide to some of the most popular kits.
Middle School: Moving Into Real-World Science
- Blood Typing Kit – The ABO/Rh Simulated Blood Typing Kit lets students test “blood” samples without ever facing a real needle.
- Intro Chemistry Kit – The Complete Introduction to Chemistry Kit offers safe, structured experiments.
- STEM Kits – Try the Basic Circuit Kit to spark creativity in engineering and technology.
- Physical Science Kits – We offer both the Physical Science Level B Kit and Physical Science Level C Kit to support our middle school and high school courses.
These kits support courses like Physical Science Explored and Experience Chemistry.

High School: Preparing for College & Beyond
High school science can feel intimidating, but the right kits make it not only doable but exciting:
- Dissection Kits – The Advanced Dissection Tools kit is perfect for Experience Biology. Pair it with specimens like earthworm, frog, crayfish, or even a sheep brain.
- Biology Kits – Our Experience Biology Lab Kit and Biology Lab Kit (Cornerstone Edition) provide all the tools needed for dissections and labs.
- Chemistry Kits – Our Experience Chemistry Lab Kit ensures students have “everything you need and nothing you don’t” for lab experiments.
- Physics Kits – Our Discover Physics Kit supports Discover Physics with hands-on lab components.
- Marine Biology Kit – The Marine Biology Lab Kit is a great option for high schoolers fascinated by the ocean and its creatures.
These high school kits prepare your student for college-level science while keeping Christ at the center.

Where to Buy Christian Homeschool Science Kits
Here are three trusted suppliers we recommend:
- Journey Homeschool Academy Bookstore: Our curated lab kits pair directly with JHA courses, making it simple to get everything you need in one place.
- Home Science Tools: Offers an extensive collection of science kits and tools for every grade level.
- Cornerstone Educational Supply: Specializes in homeschool-friendly, faith-integrated lab kits designed to match our JHA curriculum.
Pair these resources with Journey Homeschool Academy’s courses for a complete science education rooted in faith.

Why Faith + Science Kits Go Hand in Hand
As Christian parents, we know that science isn’t just about memorizing facts—it’s about worship. When our children dissect a frog or grow a butterfly, they’re not just learning biology; they’re marveling at God’s design.
Psalm 19 reminds us, “The heavens declare the glory of God; the skies proclaim the work of His hands.” Science kits give us practical tools to help our children see and celebrate that truth in a hands-on way.
Final Thoughts: You Don’t Have to Be a Scientist
You don’t need a PhD or a chemistry lab in your garage to give your kids a robust science education. All you need are the right tools—and that’s why Christian homeschool science kits are selling out so quickly.
At Journey Homeschool Academy, our mission is to equip you and inspire your kids to see God’s glory in every corner of creation. With the right course and the right kit, you’ll be amazed at how much fun science can be.
👉 Explore our courses today and get ready to make science the highlight of your homeschool week!
Recent Comments